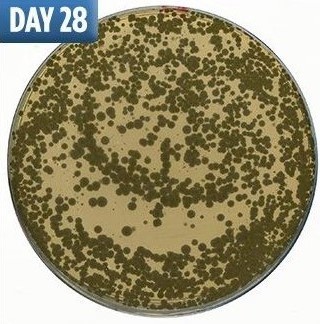

不洗床單「滿滿細菌陪你睡」 大學研究公開「細菌滋生圖」秒懂多髒
2019年06月11日你多久洗一次床單?一星期?兩星期?還是一個月?很多人覺得,我們每天睡前都會洗澡,個把月不洗床單沒關係。但西班牙的一項實驗發現,床單上的細菌會隨著時間而增加,其中有些細菌還很危險。
▼去年時,英國的床上用品零售商進行了一項調查,結果發現,25%的受訪者習慣一個月清洗一次床單被褥。西班牙塞維利亞大學進行了一項實驗,他們請志願者在一張床上睡28個晚上,並觀察床上用品的細菌量,結果非常驚人。

▼實驗第7天,培養皿中已經有細菌生長。隨著時間的推移,細菌越來越多,到了第28天,培養皿中甚至出現了與肺炎、闌尾炎相關的危險細菌,比如會引發雷米爾氏症的梭桿菌目細菌。


▼這些可怕的細菌主要來自皮膚、口腔和糞便。床單的末段放線菌屬細菌比較多;枕頭部分梭菌目、擬桿菌目、梭桿菌目和奈瑟菌目的細菌比較多。


▼美國北卡羅來納州立大學曾經有一項研究,發現一般人類的床鋪比黑猩猩巢穴中的細菌種類要多,現在看來確實如此。
▼不希望自己的床滿是細菌,至少每兩週就要換洗一次床上用品。資深家務助理導師Winnie Cheung建議,洗床單時,過清水過程中加入白醋,能夠殺菌、除臭。清潔床褥時,用抽濕機抽走濕氣,並用40°C的溫水洗抹布,再用濕抹布擦拭床褥,最後將白醋與水1:20混合,順時針擦拭除臭。

床單是最貼近人體的,上面沾染著脫落的皮膚細胞、毛髮、汗水等等,如果不經常清洗,每晚都會有無數細菌陪你睡。這不僅對皮膚不好,還會引發很多健康問題。至少2週換洗一次床單,養成良好的衛生習慣吧~
來源:the sun









